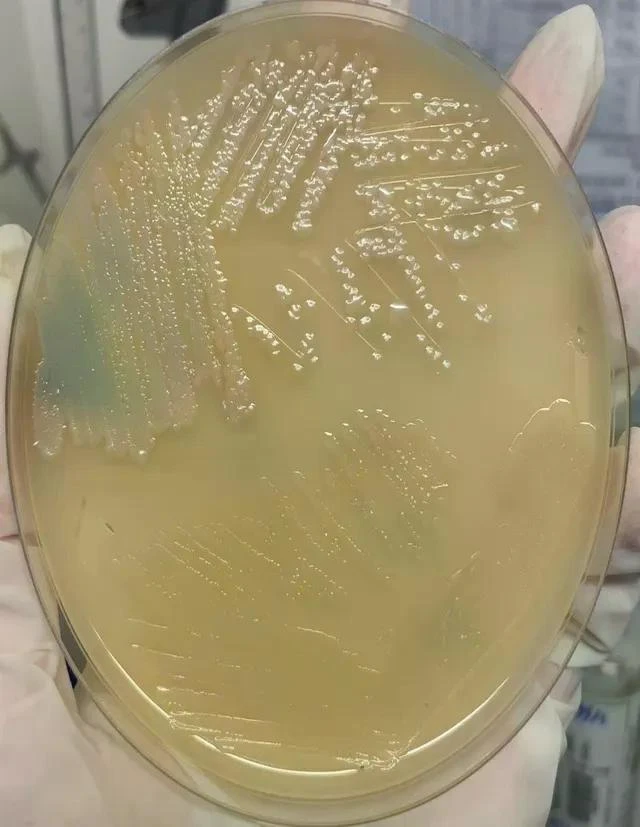
Kết quả cấy máu của bệnh nhân H.N.T.

Các bệnh nhân nhập viện trong tình trạng nặng, suy hô hấp phải thở máy, nhiễm trùng huyết, suy đa tạng, viêm - tràn dịch màng phổi, có ổ áp xe ở gan và mô mềm. Người bệnh được chẩn đoán kịp thời, điều trị tích cực theo phác đồ, hội chẩn nhiều chuyên khoa. Hiện tại, 1 bệnh nhân đã ổn định, cai được máy thở. Bệnh nhân còn lại vẫn đang trong tình trạng nguy kịch, phải dùng thuốc nâng huyết áp, thở máy, lọc máu liên tục, kháng sinh phối hợp.
Bệnh nhân thứ nhất là H.N.T., (43 tuổi, trú tại Đà Bắc, Hòa Bình), đi làm công nhân ở một tỉnh phía Nam được hơn 10 năm, công việc hàng ngày là đi giao hàng đông lạnh cho các đại lý.
Cách vào viện khoảng hơn 1 tháng, bệnh nhân xuất viện sốt cao liên tục, đã đi khám và điều trị nhưng tình trạng sốt chỉ thuyên giảm, không khỏi hẳn. Ngày 28/8/2024, gia đình ký bệnh án xin cho bệnh nhân thôi điều trị để về quê (Hoà Bình).
Ngay khi về đến Hòa Bình, bệnh nhân nhập Bệnh viện Đa khoa tỉnh Hòa Bình trong tình trạng sốt cao, rét run, suy hô hấp, sốc nhiễm khuẩn - suy đa tạng. Bệnh nhân nhanh chóng được thở máy, lọc máu liên tục, dùng thuốc vận mạch, sử dụng kháng sinh phổ rộng, trong đó có kháng sinh đặc trị bệnh Whitmore.
Kết quả cận lâm sàng cho thấy bệnh nhân bị viêm - tràn dịch màng phổi 2 bên, áp xe gan, nhiễm khuẩn huyết do vi khuẩn gây bệnh Whitmore (Burkholderia pseudomalle). Hiện tại, bệnh nhân vẫn trong tình trạng nguy kịch, đang được điều trị, chăm sóc tích cực và hội chẩn nhiều chuyên khoa.
Bệnh nhân thứ 2 là B.T.C., (59 tuổi, trú tại Lạc Sơn, Hòa Bình), có tiền sử bị bệnh đái tháo đường. Cách vào viện 1 tuần, bệnh nhân xuất hiện sốt cao, sưng - nóng - đỏ - đau vùng cổ tay bên phải, ho và khó thở tăng dần. Cùng ngày vào viện, bệnh nhân khó thở nhiều hơn, đau tức ngực, được người nhà đưa đến Trung tâm Y tế huyện cấp cứu, sau đó được chuyển đến Bệnh viện Đa khoa tỉnh Hòa Bình.
Khi nhập Bệnh viện Đa khoa tỉnh Hòa Bình, bệnh nhân trong tình trạng suy hô hấp, phải hỗ trợ bằng thở máy không xâm nhập, sốt cao liên tục, rét run, thể trạng nhiễm trùng - nhiễm độc, ho nhiều đờm, có ổ áp xe vùng cổ tay bên phải, chụp cắt lớp vi tính có hình ảnh đám mờ đông đặc và tràn dịch màng phổi 2 bên. Bệnh nhân nhanh chóng được cấy máu, nội soi phế quản bơm rửa phổi lấy bệnh phẩm làm xét nghiệm. Kết quả xét nghiệm máu và dịch phế quản cho thấy bệnh nhân bị nhiễm vi khuẩn gây bệnh Whitmore.
Bệnh nhân được điều trị theo phác đồ dưới hướng dẫn của kháng sinh đồ, hơn 1 tuần điều trị, hiện tại đã qua cơn nguy kịch, kết quả xét nghiệm chức năng các tạng: phổi - gan - thận đã cải thiện nhiều. Dự kiến, bệnh nhân sẽ xuất viện sau khoảng 1 tuần nữa và tiếp tục điều trị duy trì bằng thuốc uống từ 3 đến 6 tháng tại nhà.
Bệnh Whitmore là một bệnh nhiễm trùng ở người và động vật do vi khuẩn Burkholderia pseudomallei gây ra. Vi khuẩn sống trong đất, nước bị nhiễm khuẩn và xâm nhập vào cơ thể con người chủ yếu qua các vết thương ở da, niêm mạc.
Tại Việt Nam, ca bệnh đầu tiên được ghi nhận năm 1925, sau đó bệnh xuất hiện tại các địa phương trong cả nước và gia tăng trong thời gian gần đây. Bệnh có biểu hiện lâm sàng rất đa dạng, khó chẩn đoán và tỷ lệ tử vong cao ở những trường hợp viêm phổi nặng, nhiễm trùng huyết và sốc nhiễm trùng. Những người có bệnh nền (tiểu đường, bệnh gan, thận, phổi mạn tính) có nguy cơ cao mắc bệnh. Đặc biệt, bệnh rất dễ bị chẩn đoán nhầm với các bệnh nhiễm khuẩn khác, dẫn đến chậm trễ trong điều trị. Vi khuẩn gây bệnh Whitmore phải được điều trị bằng kháng sinh đặc hiệu, quá trình điều trị kéo dài (thường từ 3 đến 6 tháng) mới đảm bảo bệnh không tái phát.
Năm 2019 - 2020, Bệnh viện Đa khoa tỉnh Hòa Bình đã chẩn đoán, điều trị thành công 5 ca bệnh Whitmore nặng có suy đa tạng.
Hiện nay chưa có vaccine phòng bệnh. Người dân cần trang bị các dụng cụ bảo hộ cá nhân như ủng và găng tay không thấm nước để bảo vệ chân tay, chống tiếp xúc với đất, nước bị nhiễm bẩn. Khi không may có vết thương rách da, trầy xước thì cần rửa sạch vết thương dưới vòi nước sạch bằng xà phòng và đến ngay cơ sở y tế gần nhất để được xử trí kịp thời.




































